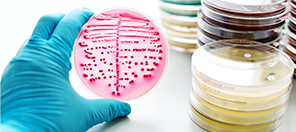

服务领域广泛

- 高分子材料检测
- 电子通讯检测
- 生态环境检测
- 食品及农化产品
- 化妆品及消毒品
- 生物医药检测
- 其他产品咨询
-
高分子材料检测
熟知各类产品的材料特性,为客户提供材料检测、分析、测试鉴定、法规咨询等专业技术服务,与广大新材料领域的客户一起推动技术革新,提升产品质量。
-
橡胶/塑料产品检测
物理性能检测、力学性能检测、热学性能检测、可靠性检测等。
-
胶黏剂/涂料/油墨产品检测
VOC检测、环境可靠性检测、机械可靠性检测、综合可靠性检测等。
-
表面处理剂产品检测
助剂有害物质检测、理化指标检测等。
-
油品及润滑产品检测
油液检测、油液特色检测、润滑产品理化性能检测等。
-
纺织/造纸等轻工化学品检测
面料或纤维中功能性检测、有机化合物检测、理化性能检测等。
-
有害物质检测
重金属含量检测、卤素检测、PCP检测、甲醛含量检测等。
-
电子通讯检测
安全可靠是产品制造环节至关重要的因素之一,微谱凭借十余年检测分析测试技术积累,为先进制造领域客户提供专业技术服务,为产品制造质量安全保驾护航。
-
电子通讯产品检测
机械性能、热分析、电性能、内部结构形貌分析、表面异物、污染物分析等。
-
新能源电池材料检测
电性能、环境适应性、安全性等。
-
光伏与锂电产品检测
安全性检测、可靠性检测、电性能检测、法规类检测认证等。
-
化学有害物质检测
RoHS检测、REACH检测、VOC检测、多环芳烃(PAHs)检测等。
-
产品质量鉴定
机电类、化工类、轻工类、建材类等 产品质量鉴定。
-
车辆及零部件检测
环境可靠性、电磁兼容EMC检测、失效分析等。
-
生态环境检测
微谱专注于环境专项检测领域,其中二噁英检测、二噁英削减和控制标准、监测数据诊断及减排技术具备行业优势。微谱用科技的力量守护人类生存环境,创造美好生态家园。
-
二噁英检测
常规检测、二噁英削减和控制标准、监测数据诊断及减排技术等。
-
土壤及地下水检测
质量检测、理化指标检测、金属指标检测、有机检测指标、微生物指标检测等。
-
固废检测
污泥检测、废渣检测、蒸馏废液检测等。
-
压缩空气检测
惰性气体检测、工业废气检测、活泼气体检测、有毒有害气体检测等。
-
生物质燃料检测
元素分析、灰熔点检测、发热量检测、物理指标检测等。
-
土壤场地调查
采用系统的调查方法,确定场地是否被污染及污染程度和范围的过程。
-
食品及农化产品检测
微谱为食品农产品及相关公司提供研发助力,生产质控,功能及安全性评价,检测备案一站式综合服务,主要包括宠物食品,乳制品,保健食品,农化产品及添加剂等产品。
-
宠物食品AAFCO检测
重金属及其他有害物质检测、微生物检测、营养及功效成分等。
-
食用油、风味物质检测
食用植物油,花生油、豆油、菜籽油、茶籽油等产品检测等。
-
农用化学品检测
除草剂检测、杀虫剂检测、化肥检测等。
-
接触材料及添加剂检测
食品接触材料检测、保健食品安全功效检测、各种添加剂检测等。
-
饲料检测
有益微生物检测、氨基酸检测、重金属元素检测等。
-
营养成分、功效成分检测
黄酮类、多酚、有机酸,维生素甾醇类物质、皂苷类物质等检测服务。
-
化妆品及消毒品检测
微谱深耕行业十余年,依据国内外相关法规,为化妆品、消毒产品、日化品提供专业检测、产品功效评价等服务,助力企业产品构思、研究开发、质量控制、上市宣传等技术需求。
-
化妆品及原料检测
原材料检测、配方成分列表分析、生产工艺指导等。
-
禁限用物质检测
风险物质检测、抗生素检测、激素检测、性激素检测等。
-
消毒产品检测
有效成分含量及稳定性检测、消毒产品质控、消毒器械检测等。
-
功效及安全性评价
化妆品功效评价、消毒剂/化妆品毒理评价、洗护用品功效及安全性评价等。
-
备案服务
进口/国产化妆品备案、特殊/非特殊化妆品备案、消毒剂备案等。
-
法规咨询
化妆品申报咨询、消毒剂申报咨询、化妆品功效评价咨询。
-
生物医药检测
作为值得信赖的医药研发合作伙伴,微谱具有丰富的药品生命周期研究经验,将实验室分析测试技术和谱图云数据相结合,为医药企业提供定制化,精准化的研究技术服务。
-
药物辅料放行检测
重金属检测、溶剂残留检测、功能性研究、安全性研究等。
-
微生物检测
微生物限度检查、无菌检查和细菌内毒素检查等。
-
药包材相容性研究
终产品相容性研究、工艺组件相容性研究、给药器具相容性研究、毒理评价等。
-
医疗器械研究测试
化学表征、降解产物研究、工艺过程污染物及残留物研究、测试服务等。
-
基因毒性杂质及元素杂质研究
杂质谱分析、杂质的分离鉴定、杂质的合成与表征等。
-
容器密封性检测
密封性能测试、气密性试验检测、自密性检测、热合强度检测等。
特色检测项目

-

理化性能检测

-

环境可靠性检测

-

有毒有害检测

-

专项检测

-

防火阻燃检测

-

成分分析

-

大型仪器测试

-

其他检测项目
关于我们
已与包括众多500强企业在内的14万+家客户建立了合作,服务地区覆盖中国及多个海外地区。
-

1100+套大型精密检测仪器
-

400+万条谱图数据
-

3000+人专业技术人才
-

8万+平方米实验室及办公
-

14万+家服务客户
-
专业公正
公正、信赖
第三方检测机构 -
经验丰富
10多年检测服务经验
多部门协同工作 -
价格透明
统一报价
无隐形消费 -
服务周到
工程师全程
一对一服务
服务领域广泛


Q:你们的报告认可度高吗?
A、微谱检测实验室通过CNAS认证,获得CMA资质认证。
Q:你们出报告的速度快吗?
A、微谱检测,多个部门协同合作
B、检测技术完善,版本升级2.0,拥有自动化样品处理、样品管理系统、省去了大量人工处理环节,更快更准确!
遍布全国的科研实验室

流程简易、暖心、效率高


 高分子领域
高分子领域 精细化学品
精细化学品 化妆及消毒品
化妆及消毒品 环境检测
环境检测 生物医药
生物医药 金属领域
金属领域 食品领域
食品领域 热门行业
热门行业 我们的服务
我们的服务